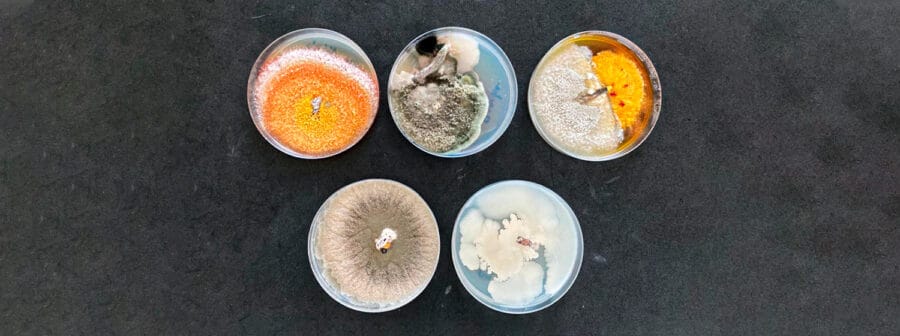

agosto 21, 2023
Mira el tercer capítulo de la serie documental sobre la protección de cerezos en Chile contra la Botrytis, de nuestros amigos de FRUTICULTURA. En esta ocasión, nuestra experta en microbiología beneficiosa, la Ingeniera agrónoma Claudia Agurto, explora los conceptos fundamentales de la microbiota beneficiosa. Conocimos las herramientas con que contamos para mitigar la Botrytis (productos comerciales). Finalmente, nuestra experta nos entrega estrategias prácticas para implementar esta tecnología en la producción de cerezas. Infórmate cómo la microbiología beneficiosa está cambiando la forma en que enfrentamos la Botrytis en los cerezos chilenos.